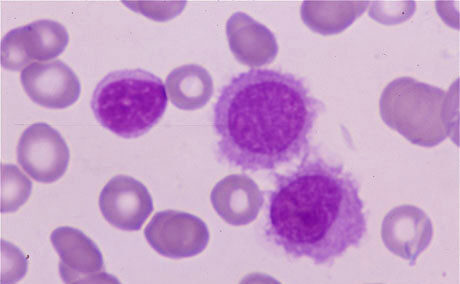
Leucemia de células pilosas

La leucemia de células pilosas (LCP) se clasifica como una malignidad poco común que afecta a las células madre hematopoyéticas, específicamente a los linfocitos B maduros con características morfológicas distintivas, incluidas proyecciones citoplasmáticas pilosas. Este tipo de leucemia se caracteriza por la acumulación anormal de linfocitos B maduros con proyecciones pilosas en la médula ósea, la sangre periférica y, en ocasiones, en el bazo.
El evento genético causal identificado en la leucemia de células pilosas es la variante patogénica V600E en el gen BRAF. El gen BRAF, un miembro de la familia de las serina/treonina quinasas, es conocido por su papel en la regulación de la proliferación celular y la supervivencia. La variante V600E es una mutación específica que se caracteriza por la sustitución de valina (V) por glutamato (E) en la posición 600 del gen BRAF. Esta mutación conduce a una activación constitutiva de la proteína BRAF y a la activación aberrante de la vía de señalización MAPK (quinasa activada por mitógenos), lo que promueve la proliferación celular descontrolada y la supervivencia celular prolongada.
Se ha observado que la variante V600E en el gen BRAF está presente en casi todos los casos de leucemia de células pilosas al momento del diagnóstico y también se encuentra en recurrencias de la enfermedad. Esta alta prevalencia sugiere un papel crucial de esta mutación en la patogénesis de la leucemia de células pilosas.
La LCP se considera una malignidad rara debido a su baja incidencia en comparación con otras formas de leucemia. Esta rareza puede deberse a la especificidad de la enfermedad, que se caracteriza por características morfológicas distintivas y por la asociación casi universal con la variante V600E en el gen BRAF.
Hallazgos clínicos
La leucemia de células pilosas es una enfermedad hematológica que presenta características clínicas distintivas, incluyendo una incidencia notable en hombres de mediana edad, con una edad media al inicio de aproximadamente 55 años, y una marcada predominancia masculina con una proporción de 5 hombres por cada mujer afectada.
Los pacientes con leucemia de células pilosas suelen experimentar un inicio gradual de fatiga, que es uno de los síntomas más comunes. Además, algunos pacientes pueden quejarse de síntomas relacionados con un agrandamiento notable del bazo, mientras que otros pueden llamar la atención debido a infecciones recurrentes. La esplenomegalia, o agrandamiento del bazo, está casi invariablemente presente en los pacientes con LCP y puede ser masiva. Aproximadamente la mitad de los casos también presentan agrandamiento del hígado, mientras que la linfadenopatía, o agrandamiento de los ganglios linfáticos, es poco común en esta enfermedad.
La leucemia de células pilosas suele ser un trastorno indolente, lo que significa que progresa lentamente con un curso clínico crónico. Los pacientes con LCP suelen experimentar pancitopenia, que es una disminución en el número de glóbulos rojos, glóbulos blancos y plaquetas en la sangre. Esta pancitopenia puede predisponer a los pacientes a infecciones recurrentes, que son una complicación común de la enfermedad. Es importante destacar que las infecciones micobacterianas, causadas por bacterias del género Mycobacterium, también pueden ser una complicación significativa en los pacientes con leucemia de células pilosas.
Hallazgos de laboratorio
La leucemia de células pilosas es tiene varias características distintivas:
- Pancitopenia: La pancitopenia es la reducción en el número de glóbulos rojos, glóbulos blancos y plaquetas en la sangre periférica. En la LCP, la infiltración de la médula ósea por células leucémicas causa una supresión de la producción normal de células sanguíneas. Como resultado, los pacientes con LCP suelen presentar anemia (disminución de los glóbulos rojos), trombocitopenia (disminución de las plaquetas) y neutropenia (disminución de los glóbulos blancos).
- Anemia, trombocitopenia y neutropenia: Estas son manifestaciones comunes en la LCP. La anemia es casi universal en los pacientes con LCP, lo que provoca fatiga y debilidad. La trombocitopenia y la neutropenia ocurren en aproximadamente el 75% de los pacientes, lo que puede conducir a un mayor riesgo de hemorragia y infección, respectivamente.
- Presencia de células pilosas en frotis de sangre periférica: Las células pilosas, que son características de la LCP, se pueden observar en pequeñas cantidades en el frotis de sangre periférica. Estas células tienen proyecciones citoplasmáticas largas y delgadas que se asemejan a pelos y son una manifestación visual distintiva de la enfermedad.
- Inaspirabilidad de la médula ósea: Debido a la infiltración de la médula ósea por células leucémicas, la médula ósea en pacientes con LCP suele ser inaspirable mediante una punción seca. Esto significa que la extracción de médula ósea para el diagnóstico mediante aspiración no es exitosa, y se requiere una biopsia de médula ósea para evaluar la morfología característica de las células pilosas.
- Patrón de tinción histoquímica con TRAP: Las células pilosas en la LCP muestran un patrón de tinción positivo para fosfatasa ácida resistente al tartrato (TRAP). Esta característica histoquímica es útil en el diagnóstico y la diferenciación de la LCP de otras enfermedades similares.
- Coexpresión de antígenos en la inmunofenotipificación: En la inmunofenotipificación, las células leucémicas de la LCP suelen coexpresar varios antígenos, incluyendo CD11c, CD20, CD22, CD25, CD103 y CD123. Estos marcadores son útiles para caracterizar las células leucémicas y confirmar el diagnóstico de LCP.
- Infiltración marcada de la pulpa roja en el bazo: En el examen patológico del bazo, se observa una infiltración marcada de la pulpa roja con células pilosas en pacientes con LCP. Esta característica contrasta con la predilección habitual de los linfomas por involucrar la pulpa blanca del bazo, lo que puede ayudar en el diagnóstico diferencial entre la LCP y otros trastornos hematológicos.
Diagnóstico diferencial
La distinción de la leucemia de células pilosas (LCP) de otras enfermedades linfoproliferativas que afectan la médula ósea, así como de otras causas de pancitopenia, es fundamental debido a las diferencias significativas en el tratamiento, el pronóstico y la gestión clínica. La LCP se caracteriza por la presencia de células pilosas en la sangre periférica y la médula ósea, así como por la expresión de marcadores específicos en la inmunofenotipificación. Estas características son esenciales para distinguir la LCP de otras formas de leucemia, como la leucemia linfocítica crónica (LLC) o la leucemia linfoblástica aguda (LLA), así como de otros trastornos linfoproliferativos, como el linfoma.
La pancitopenia, una reducción en los niveles de glóbulos rojos, glóbulos blancos y plaquetas en la sangre, es una característica distintiva de la LCP. Sin embargo, también puede ser observada en otras condiciones, como el hiperesplenismo debido a diversas causas, anemia aplásica y hemoglobinuria paroxística nocturna. Por lo tanto, es fundamental realizar una evaluación completa para identificar la causa subyacente de la pancitopenia y diferenciarla de la LCP.
El tratamiento y el pronóstico de la LCP difieren significativamente de otras enfermedades linfoproliferativas y causas de pancitopenia. Por ejemplo, la LCP puede responder favorablemente a agentes específicos como el cladribina o el rituximab, mientras que otras condiciones pueden requerir enfoques terapéuticos diferentes. Un diagnóstico preciso es crucial para proporcionar el tratamiento más efectivo y mejorar el pronóstico del paciente.
La prevención de errores diagnósticos y el manejo inapropiado son aspectos críticos en la gestión de pacientes con LCP. La confusión entre la LCP y otras enfermedades puede llevar a retrasos en el tratamiento adecuado o la administración de terapias inadecuadas y potencialmente perjudiciales. Una identificación precisa de la enfermedad subyacente permite un manejo óptimo y una mejor calidad de vida para el paciente.
Tratamiento
El tratamiento de la leucemia de células pilosas (LCP) se reserva típicamente para aquellos pacientes que presentan síntomas significativos, como malestar esplénico, infecciones recurrentes o citopenias (disminución en el número de células sanguíneas) que afectan negativamente su calidad de vida o aumentan el riesgo de complicaciones graves. Estas indicaciones para el tratamiento se basan en la necesidad de aliviar los síntomas del paciente y prevenir complicaciones relacionadas con la enfermedad.
El tratamiento de elección para la LCP es un análogo de nucleósidos, específicamente pentostatina o cladribina, administrado en un curso único. Estos medicamentos han demostrado producir remisiones completas en un alto porcentaje de pacientes, que oscila entre el 70% y el 95%. La remisión completa implica la desaparición completa de los signos y síntomas de la enfermedad, así como la normalización de los recuentos sanguíneos.
Sin embargo, el tratamiento de la LCP está asociado con complicaciones, especialmente infecciones, debido a la supresión del sistema inmunológico. Por lo tanto, es fundamental que los pacientes sean monitoreados de cerca durante el tratamiento y se tomen medidas para prevenir y tratar cualquier complicación que pueda surgir.
A pesar de estas complicaciones, la duración media de la respuesta al tratamiento es notablemente prolongada, con una media de más de 8 años. Esto significa que la mayoría de los pacientes experimentan una remisión duradera después del tratamiento inicial. Además, los pacientes que experimentan una recaída después de un año o más de la terapia inicial pueden recibir tratamiento nuevamente con uno de estos agentes, lo que demuestra la eficacia a largo plazo de estos medicamentos.
En el entorno de recaída, el rituximab, un anticuerpo monoclonal dirigido contra el antígeno CD20 presente en las células B, puede ser utilizado como agente único o en combinación con un análogo de nucleósidos. Esto proporciona una opción adicional de tratamiento para los pacientes que experimentan una recaída de la enfermedad.
Además, el inhibidor de BRAF vemurafenib ha mostrado una tasa de respuesta global excepcionalmente alta de aproximadamente el 100% en pacientes con LCP refractaria o recurrente. Este medicamento puede inducir remisiones completas en un porcentaje significativo de pacientes, lo que ofrece una opción terapéutica prometedora para aquellos que no responden a los tratamientos convencionales.
Sin embargo, a pesar de estas opciones de tratamiento, la supervivencia libre de recaída varía entre los pacientes que logran una remisión completa y aquellos que solo obtienen una respuesta parcial. En promedio, la supervivencia libre de recaída es de aproximadamente 19 meses en pacientes con remisión completa y 6 meses en aquellos con respuesta parcial. Esto subraya la importancia de una vigilancia continua y un manejo individualizado para optimizar los resultados del tratamiento en pacientes con LCP.
Pronóstico y evolución
La alta tasa de supervivencia a largo plazo en pacientes con leucemia de células pilosas (LCP), donde más del 95% vive más de 10 años, se atribuye a una combinación de factores biológicos, avances en el diagnóstico y tratamiento, así como una atención médica de apoyo integral.
La leucémia de células pilosas se caracteriza por su baja agresividad en comparación con otras formas de leucemia. Esta enfermedad progresa de manera gradual, lo que permite un manejo más efectivo y menos agresivo. Además, los tratamientos estándar para la LCP, como los análogos de nucleósidos como la pentostatina y la cladribina, han demostrado ser altamente efectivos. Estos tratamientos pueden inducir remisiones completas en la gran mayoría de los pacientes, lo que lleva a una supresión duradera de la enfermedad y, en muchos casos, a la curación.
La mejora en la atención médica de apoyo también ha desempeñado un papel crucial en la supervivencia a largo plazo de los pacientes con LCP. Esto incluye medidas para prevenir y tratar las complicaciones asociadas con la enfermedad y su tratamiento, como las infecciones. La vigilancia continua y el manejo individualizado de los pacientes permiten ajustar el tratamiento según las necesidades específicas de cada paciente, lo que contribuye a los resultados a largo plazo.
Además, la investigación continua en el campo de la LCP ha llevado al desarrollo de nuevas terapias y enfoques de tratamiento. Esto incluye el descubrimiento de nuevos agentes terapéuticos dirigidos específicamente a las características moleculares de la enfermedad, así como el refinamiento de las estrategias de tratamiento existentes.